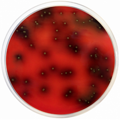
E-shop hlavní obrázek

Selektivní a diferenciální médium pro detekci Listeria spp., zejména Listeria monocytogenes.
Produkt je dodáván v dehydratované formě a je určen pro přípravu hotových kultivačních médií.

Antibiotické disky jsou papírové disky se speciálními vlastnostmi, které jsou impregnovány antibiotiky a používají se pro testování dle Kirby-Bauer metody stanovení antibiotické citlivosti.

Antibiotické disky jsou papírové disky se speciálními vlastnostmi, které jsou impregnovány antibiotiky a používají se pro testování dle Kirby-Bauer metody stanovení antibiotické citlivosti.

Fixační roztok pro barvení dle Grama.

Lugolův roztok, připraveno k použití, 500 ml

BlueDot Lupus IgG je imunodot souprava určená pro detekci autoprotilátek IgG v lidském séru proti Nucleosome, Histones, Sm a Ribosome P0 antigenům.

Diatabs™ identifikační tablety určené ke kvalitativní detekci mikrobiálních charakteristik při identifikaci mikroorganismů.

MacConkey agar je selektivní a diagnostická půda, která se používá pro izolaci, kultivaci a diferenciaci Gram-negativních mikroorganismů, zejména Enterobacteriacae.

MacConkey agar se sorbitolem se používá pro izolaci enteropatogenního E. coli O157:H7.

Kultivační půda používaná pro izolaci a identifikaci enterobakterií ze stolice, moči, odpadních vod a potravin. Tento produkt je dodáván v dehydratované formě a je určen pro přípravu hotových kultivačních médií.

Selektivní kultivační půda určená pro E.coli 0157:h7. Tento produkt je dodáván v dehydratované formě a je určen pro přípravu hotových kultivačních médií.

MacConkey bujón je určen pro detekci koliformních organismů ve vodě, mléce a dalších materiálech sanitárního významu.
Tento produkt je dodáván v dehydratované formě a je určen pro přípravu hotových kultivačních médií.

MAL agar rozšířuje a zlepšuje podmínky pro izolaci a diferenciaci patogenních střevních mikroorganismů, které poskytuje XLD agar. Je určený k záchytu sirovodík pozitivních salmonell (jiných než S.typhi) a na rozlišení mannitolpozitivních a mannitolnegativních enterobakterií.

MALDI matrice určená pro použití s IVD MALDI Biotyper systémem.

Diatabs™ identifikační tablety určené ke kvalitativní detekci mikrobiálních charakteristik při identifikaci mikroorganismů.

Diatabs™ identifikační tablety určené ke kvalitativní detekci mikrobiálních charakteristik při identifikaci mikroorganismů.

Mannitol Salt Agar je selektivní médium pro izolaci a stanovení počtu stafylokoků. Používá se rovněž k diferenciaci manitol fermentujících a manitol nefermentujících druhů.

Diatabs™ identifikační tablety určené ke kvalitativní detekci mikrobiálních charakteristik při identifikaci mikroorganismů.